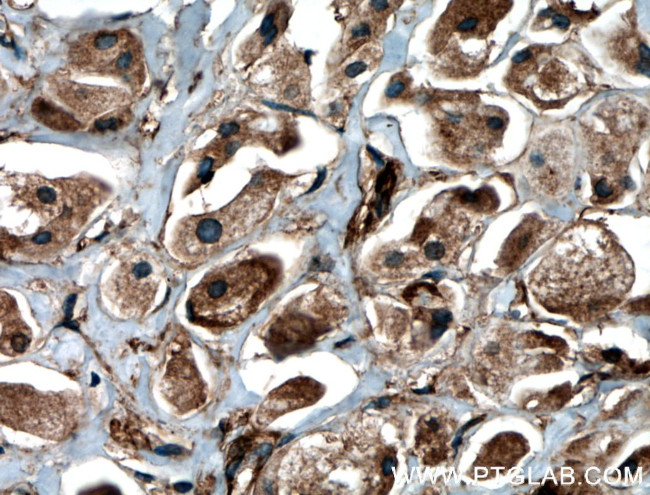
BRAP Antibody in Immunohistochemistry (Paraffin) (IHC (P))

Search
Proteintech
BRAP Polyclonal Antibody
{{$productOrderCtrl.translations['antibody.pdp.commerceCard.promotion.promotions']}}
{{$productOrderCtrl.translations['antibody.pdp.commerceCard.promotion.viewpromo']}}
{{$productOrderCtrl.translations['antibody.pdp.commerceCard.promotion.promocode']}}: {{promo.promoCode}} {{promo.promoTitle}} {{promo.promoDescription}}. {{$productOrderCtrl.translations['antibody.pdp.commerceCard.promotion.learnmore']}}
产品信息
27431-1-AP
种属反应
宿主/亚型
分类
类型
抗原
偶联物
形式
浓度
规格
纯化类型
保存液
内含物
保存条件
运输条件
产品详细信息
Immunogen sequence: RLVASKTDG KIVQYECEGD TCQEEKIDAL QLEYSYLLTS QLESQRIYWE NKIVRIEKDT AEEINNMKTK FKETIEKCDN LEHKLNDLLK EKQSVERKCT QLNTKVAKLT NELKEEQEMN KCLRANQVLL QNKLKEEERV LKETCDQKDL QITEIQEQLR D (376-535 aa encoded by BC136698)
靶标信息
Negatively regulates MAP kinase activation by limiting the formation of Raf/MEK complexes probably by inactivation of the KSR1 scaffold protein. Also acts as a Ras responsive E3 ubiquitin ligase that, on activation of Ras, is modified by auto-polyubiquitination resulting in the release of inhibition of Raf/MEK complex formation. May also act as a cytoplasmic retention protein with a role in regulating nuclear transport.
仅用于科研。不用于诊断过程。未经明确授权不得转售。
篇参考文献 (0)
生物信息学
蛋白别名: BRAP2; BRCA1-associated protein; galectin-2-binding protein; IMP; IMP; E3 ubiquitin ligase; Impedes mitogenic signal propagation; Renal carcinoma antigen NY-REN-63; RING finger protein 52; RING-type E3 ubiquitin transferase BRAP2; unnamed protein product
基因别名: BRAP; BRAP2; IMP; RNF52
UniProt ID: (Human) Q7Z569
Entrez Gene ID: (Human) 8315